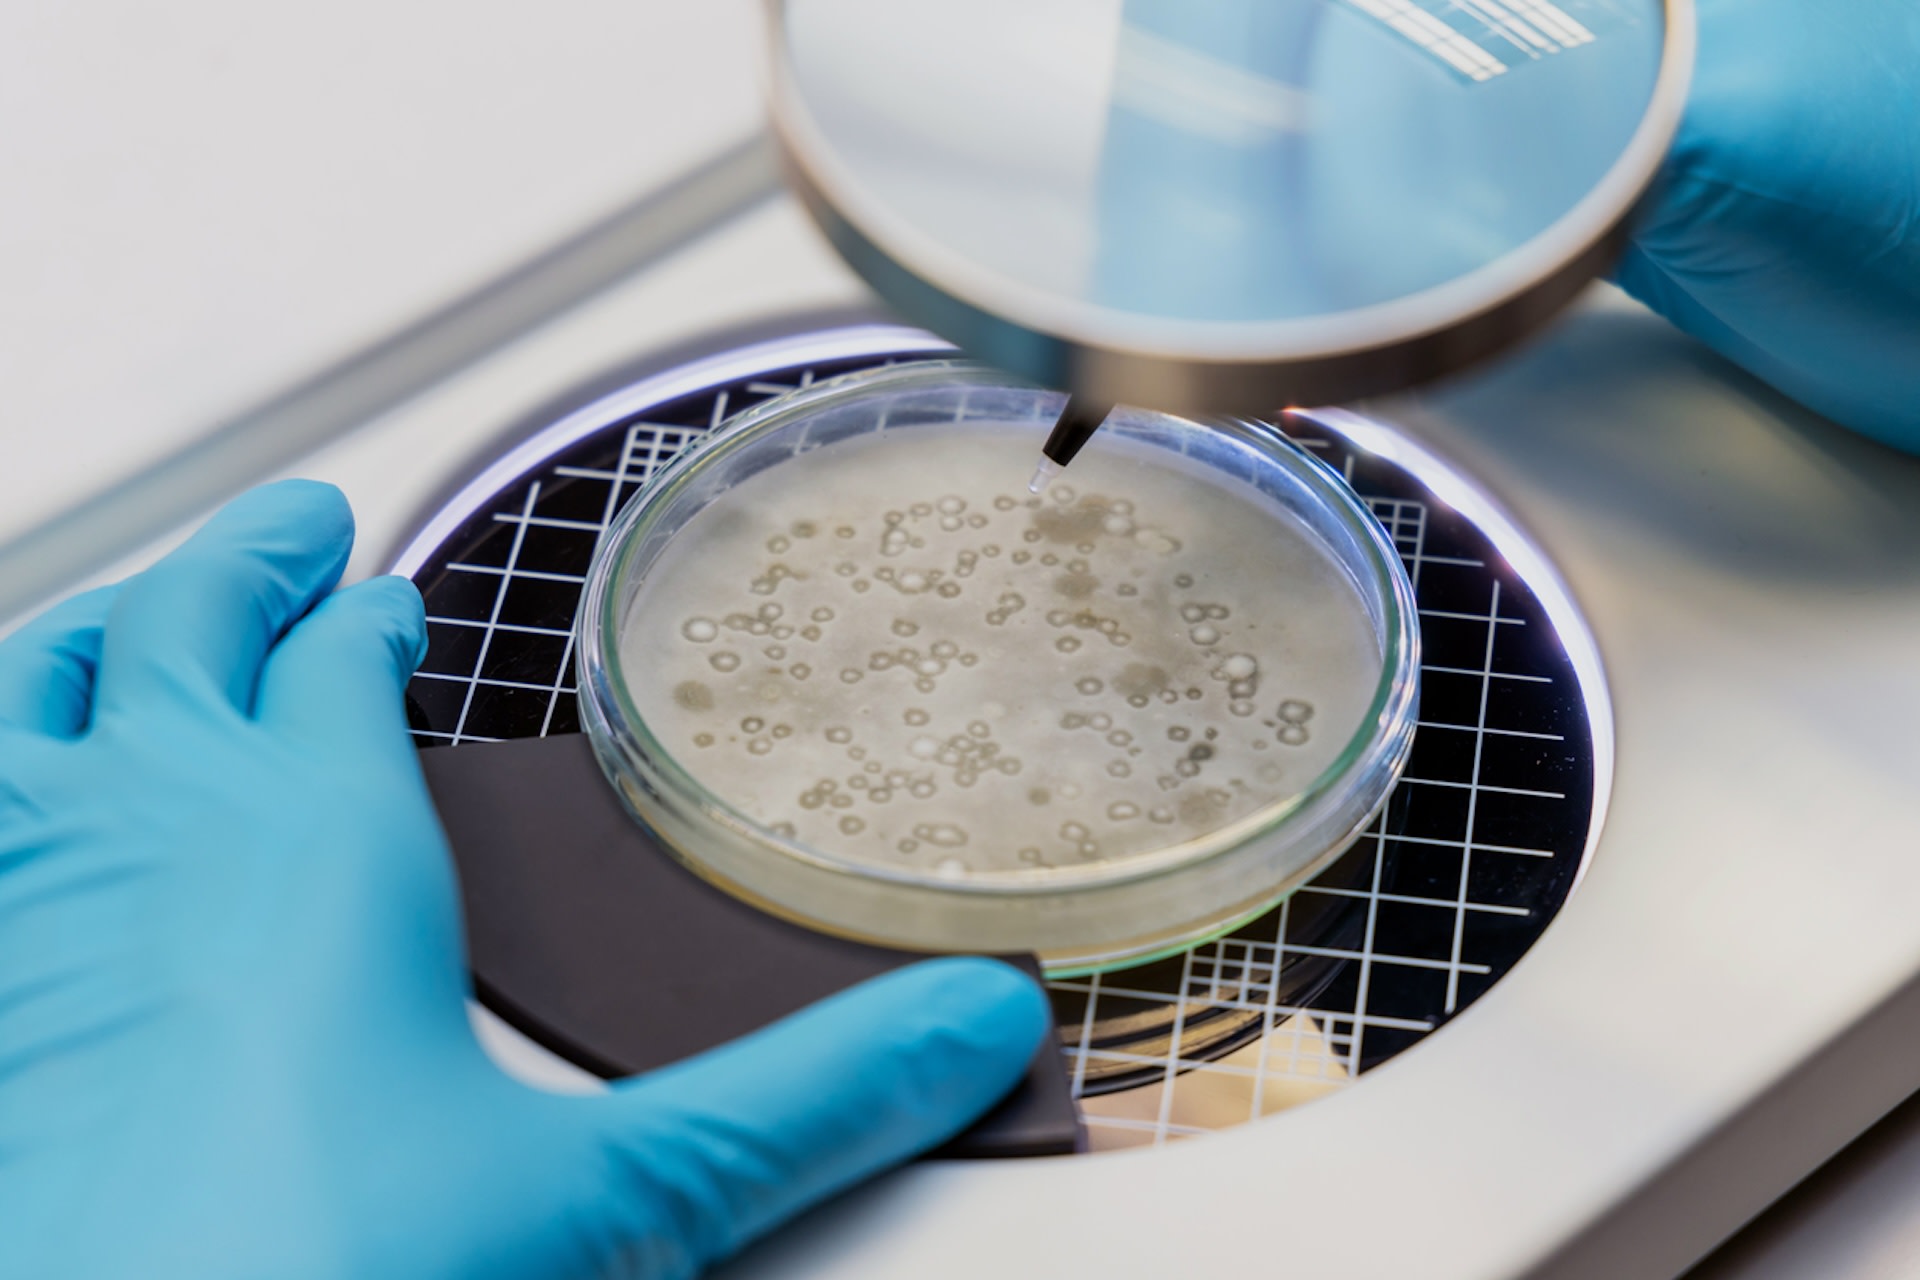

A potentially fatal fungal disease is on the rise in the U.S., and scientists say rising global temperatures could be the culprit.
What's happening?
Candida auris, a potentially fatal pathogen, has adapted to "cross" the human temperature barrier, Grist reports. Presenting as a fungal infection, C. auris started appearing in New York hospitals in 2016, but researchers found that it had been in the country since 2013.
Since 2017, cases in the U.S. have jumped by 1,200%, and some scientists think the growth is linked to a warming planet. As Grist explains, fungi can develop a tolerance for warmer environments as temperatures rise. This can help them invade the bodies of humans and other mammals, whose naturally high temperatures generally protect them from fungal pathogens. Eventually, humans can lose resistance to these fungi, becoming more vulnerable to infection.
While New York remains a hotspot for the fungus, it has been identified in 29 states and most 2023 cases were in Nevada and California, per the news outlet. Washington state recently faced its first outbreak, as four people tested positive in January. Meanwhile, it's also spreading across the globe — cases in Europe nearly doubled from 2020 to 2021.
Why is the rise of Candida auris fungal infections concerning?
After infection, this fungus can cause bloodstream, wound, and respiratory infections, along with other severe illnesses. The condition usually doesn't pose much of a threat to otherwise healthy people, but it can be especially dangerous for older patients and those with other medical conditions, according to the Centers for Disease Control and Prevention.
The pathogen is also resistant to traditional treatments and can spread fast among people — Dr. Luis Ostrosky, a professor of infectious diseases at McGovern Medical School at UTHealth Houston, told Grist he saw it spread through an entire ICU in two weeks.
Ostrosky told the publication that C. auris is "kind of our nightmare scenario." He continued, "It's a potentially multidrug-resistant pathogen with the ability to spread very efficiently in health care settings. We've never had a pathogen like this in the fungal-infection area."
C. auris isn't the only fungus-related disease on the rise due to warmer global temperatures. Scientists say extreme weather linked to climate change is causing a resurgence of a previously rare disease in California called valley fever, which can cause cough, tiredness, and chest pain. About 20% of cases can lead to more serious complications like ulcers, swollen joints, meningitis, and death.
Scientists also predict a rise in malaria, a life-threatening, mosquito-borne illness that already kills hundreds of thousands of people globally each year.
What can I do to protect myself from Candida auris?
According to the CDC, healthcare providers should take special care to separate patients infected with C. auris from others who are at risk. Rooms should be cleaned with special disinfectant products, and gowns and gloves should be worn to deliver care.
Symptoms can vary, but C. auris can cause sepsis, fever, and low blood pressure. Diagnosis can be made through a colonization screening or clinical specimen testing.
It's also crucial that we help curb the warming of our planet to help stop the proliferation of climate-fueled disease outbreaks. You can help by voting for pro-climate candidates, taking public transit when possible, or opting into renewable energy sources like community solar.
Join our free newsletter for weekly updates on the coolest innovations improving our lives and saving our planet.